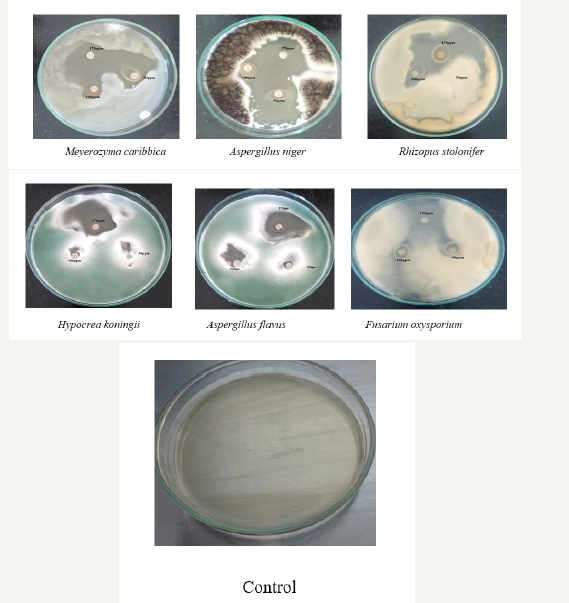
Click here to view Large image 7

R Divya, N Supraja and E Davida*
Department of Biotechnology, India
*Corresponding author: E Davida, Department of Biotechnology, India
Submission: December 06, 2018;Published: December 20, 2018
Volume2 Issue2 December 2018
Of silver nanoparticles extracellularly. The biosynthetic methods have been recognized as an alternative to chemical and physical synthesis, as this biosynthetic method is economical, ecofriendly, and cost-effective. The present work exhibited an efficient and low-cost biological approach to synthesize the metal nanoparticles and provided helpful insight into the development of new antimicrobial agents with the synergistic enhancement of the antimicrobial mechanism against pathogenic microorganisms.
A green synthesis of Zinc Oxide nanoparticles was carried out using Vitis vinifera skin peel extract. Synthesized nanoparticles were characterized using UV-Vis absorption spectroscopy, DLS, TEM, FT-IR and XRD studies respectively. UV-Vis absorption spectroscopy of prepared Zinc Oxide colloidal solution showed absorption maxima at 230nm. TEM analysis showed average particle size ranging from 0.5-10μm, while XRD confirms SAED pattern confirmed the crystalline nature of synthesized nanoparticles. FT-IR analysis revealed that primary and secondary amine groups in combination with the protein present in the peel extract are responsible for reduction reaction and also the stabilization of Zno nanoparticles. DLS shows the particle size of nanoparticles is 64.4nm and has a negative zeta potential of -34.1mV. Hence from this study we concluded that the nanoparticles synthesized from Vitis vinifera peel extract has shown very effective on in-vitro antimicrobial activity (Gram positive and negative Bacteria, Fungi) using disc diffusion method.
Keywords: Vitis vinifera; Zinc oxide nanoparticles; Antimicrobial activity
Particles with a size up to 100nm are usually referred to as nanoparticles. Nanoparticles exhibit completely new or improved properties, based on specific characteristics, such as grain size, distribution, morphology, and higher surface to volume ratio if compared with larger particles of the bulk material. A specific surface area is relevant to catalytic reactivity and other related properties, such as antimicrobial activity in Zinc Oxide nanoparticles (ZnONPs). The prefix “nano” has found much interest in last decades as an increasing application to different fields of the knowledge. Nano science, nanotechnology, nano materials, nano chemistry are some of few nano-containing terms that occur frequently in scientific reports, in popular books and also in newspapers and that have become familiar. Nanotechnology is an important field of modern scientific research that deals with synthesis, strategy and manipulation of particles structure ranging from approximately 1 to 100nm in size [1]. At this size, the atoms and molecules work differently in a dynamic way due to the change in physical chemical and biological properties. These dynamic changes provide a variety of surprising and interesting uses [2]. It provides opportunities for the development of materials that includes medical and pharmaceutical applications due to its boosting properties of materials in the form of nanosized particles. The development of green processes for the synthesis of nanoparticles has been evolving into an important branch of nanotechnology as green nanotechnology that deals with the safer and eco-friendly methods for nano materials fabrication and which is considered as an alternative to conventional physical and chemical methods [3].
Nanomaterials exhibit unique and considerably changed physical, chemical, and biological properties compared to their bulk counterparts [4]. Even though physical and chemical methods [5] are more popular for nano particle synthesis, the use of toxic compounds limits their applications [6]. For over past several years, plants, algae, fungi, bacteria, and viruses have been used for production of metallic nanoparticles [7]. Green synthesis of metallic nanoparticles from plants is been an interesting aspect as the process is ecofriendly and non-toxic. Plant and plant materials have become potential sources for the synthesis of metallic nanoparticles in recent days.
Zinc oxide nanoparticles appear to be the strong resistant agent towards bacteria and fungi [8]. The present study reports for the first time on simple and rapid biosynthesis of Zinc Oxide nanoparticles using Vitis vinifera peel extract. As prepared, Zno nanoparticles were characterized by various methods, such as UV-Vis, FT-IR, DLS, TEM and XRD for antimicrobial activity. This work provided a potential approach for the production of Zno nanoparticles without the involvement of additional chemicals and physical steps.
Figure 1:Vitis vinifera peel.

Vitis vinifera peel was collected from Acharya N G Ranga Agricultural University, Tirupati. (Figure 1). The peel was air-dried for 10 days, then kept in a hot air oven at 50°C for 24h. Peel were ground to fine powder. 10g of powder was mixed in 100ml of water and boiled at 85°C for 90min and the solution was filtered using Whatman filter paper (No.1) and the extract was collected and stored in a plastic bottle. 90ml of 1mM Zinc oxide is added to 10ml of extract and incubated for one day. A change in the color of solution was observed it indicates the formation of nanoparticles [9].
The microbes (Bacteria and fungi) samples were collected from Nanotechnology laboratory, Regional Agricultural Research Station, Tirupathi, (Chittoor District) Andhra Pradesh, India. These samples were stored in an ice box and transported to the laboratory for microbiological characterization. Through serial dilution pour plate technique, fungal sp. was isolated using potato dextrose agar (PDA) medium, and Gram negative and Gram-positive bacteria were isolated from nutrient agar medium. Further, it is maintained in potato dextrose agar slants (fungi) and nutrient agar slants (bacteria) for onward analysis.
The antibacterial activity of ZnONPs was evaluated against the pathogenic strains E. coli, Pseudomonas, Staphylococcus aureus, Klebsilia, Salmonella typhimurium and Bacillus pantothenticus. These cultures were grown in appropriate mediums at 37 °C for overnight incubation and maintained at 4 °C in a refrigerator. Disc (for disc diffusion method) of 5mm was made for nutrient agar medium and each disc was dipped at different concentrations (170, 100, 50ppm) of prepared ZnONPs. The pure cultures of bacterial pathogens were sub-cultured in an appropriate medium. After incubation at 37 °C for 24h the bacterial inhibition zones were calculated. These assays were performed in triplicate [5].
Antifungal activity of Vitis vinifera peel produced ZnONPs The antibacterial activity of AgNPs was evaluated against the pathogenic strains Aspergilus niger, Aspergilus flavus, Meyerozyma caribbica, Hypocrea koningii, Fusarium oxysporium and Rhizopus stolonifer. These cultures were grown in appropriate medium at 37 °C for overnight incubation and maintained at 4 °C in a refrigerator. Disc of 5mm was made on nutrient agar medium and each disc was dipped at different concentrations (170, 100, 50ppm) of AgNPs. The pure cultures of fungal pathogens were sub cultured in an appropriate medium and each strain was swabbed uniformly on to the individual plate. After incubation at 37 °C for 24h the inhibition zones were measured in triplicate [10].
Nanoscale particles exhibit the localized surface plasmon resonance (LSPR) phenomenon which represents the characteristic absorption spectra of the nanoparticles (formed zinc oxide nanoparticles) and was recorded using UV-Vis Spectrophotometer (50 ANALYTIKJENA) run in the wavelength range from 250 to 400nm. The FT-IR spectrum of the sample containing Zinc oxide nanoparticles was recorded by directly placing KBr crystal using ATR (attenuated total reflectance) technique in the transmittance mode and run in the mid IR region of 400-4000cm–1. X-ray diffraction technique was used to reveal the crystal structure of the prepared Zinc oxide nanoparticles. Model: JPX-8030) with CuK radiation (Ni filtered=13418 A) at 40kV, 20A. The hydrosol was filtered through a 0.22μm syringe driven filter unit and the size (hydrodynamic diameter) and distribution were measured by using the Dynamic Light Scattering (DLS) technique (Nanopartica, HORIBA, SZ-100). The surface morphological studies including size and shape of the formed zinc oxide nanoparticles were carried out by analyzing the samples under scanning electron microscope (Hitachi’s SU6600) operated at accelerating voltage of 30Kv (with the magnification ranging from 10× to 600,000), TEM (H-7100 Hitachi).
In this study, the extract when interacting with the Zinc nitrate solution forms a Pale-yellow color change indicating the biotransformation the color change was monitored visually and the peak at 250nm in the UV-visible spectra indicated the presence of ZnONPs which may be due to the excitation of surface Plasmon vibrations in ZnONPs (Figure 2). The bioreduction of zinc is extracellular and it may have a promising force in the vast development of green synthesis of metallic nanoparticles using the Plant sources.
Figure 2:Showing UV-visible spectrum of Vitis vinifera peel extract mediated synthesized ZnONPs.

Figure 3:Showing FT-IR spectrum of Vitis vinifera peel extract mediated synthesized ZnONPs.

The FT-IR spectrum shows the presence of band at 3364.19, 2926.94, 2888.07, 2107.96, 1743.97, 1637.20, 1461.01 and 1166.61cm−1 corresponding to mono-substituted amide, nitro, primary amide, carboxylic, and alcohol group, respectively. The band at 3364 and 22926cm−1 observation confirms the presence of N-H bend, indicating the primary and secondary amine groups of protein, respectively. 2888, 1743 and 1461 indicates alkanes group, the strong band of –C=O– stretch (carboxylic acids) was recorded at 1637.20cm-1. The medium bands of –C–N– stretch (aromatic amines) and -CH2–X stretch (alkyl halides) were recorded at 2107.96cm-1. And the band present at 1166.61 cm-1 indicates the presence of C–Br stretching vibration. From the FT-IR spectra of Vitis vinifera peel ZnONPs, change in wave number of the functional groups was observed due to the reduction and stabilization of metal group Zn [11] (Figure 3).
Figure 4:Showing XRD of Vitis vinifera peel extract mediated synthesized ZnONPs.

The XRD pattern of the ZnONPs is shown in (Figure 4). Bragg reflections obtained in the micrograph clearly indicated the presence of (100), (002) (101), (102), (110), (103), (200), (112), (201), (004), (202) sets of lattice planes which is a consequence of crystalline nature of formed ZnONPs and indexed as face-centeredcubic (FCC) structure of Zinc. In addition to the Bragg peaks representative of FCC AgNPs, additional as yet unassigned peaks are also observed suggesting that the crystallization of bio-organic phase occurs on the surface of the nanoparticles (Figure 4).
The hydrodynamic diameter (size) of the ZnONPs was found to be 64.4nm (Figure 5a) and was measured as a function of scattering angle of the laser from the surface of the particle. Further, zeta potential of ZnONPs was also measured and was recorded as -34.1mV (Figure 5b). The zeta potential clearly indicates stability of the prepared ZnONPs.
Figure 5a & 5b:Particle size and showing zeta potential of Vitis vinifera peel extract mediated synthesized AgNPs.

The TEM images showed that most of the particles are irregular and agglomerated spherical in shape and created big agglomerates which indicated the monodispersed nature of NPs. The TEM images revealed that ZnONPs are in the range of 0.1μm (Figure 6) [12].
Figure 6:Showing TEM analysis of Vitis vinifera peel extract mediated synthesized AgNPs.

Figure 7:showing Anti fungal activity of Vitis vinifera peel extract mediated synthesized ZnONPs.
It is well-known that Zinc Oxide nanoparticles exhibit Pale yellow color, arising due to excitation of Surface Plasmon vibrations in the Zinc nanoparticles. Zinc oxide nanoparticles shown have very strong inhibitory action against fungal sp, Gram-positive and Gramnegative bacteria. Three concentrations of NPs (170, 100, 50ppm). The higher concentration (170ppm) of AgNPs showed significant antimicrobial effect compared with other concentrations (100 and 50ppm). But when compared to fungi bacteria had shown very good antibacterial activity at 170ppm concentration (Figure 7 & 8) (Table 1 & 2).
Figure 8:showing Anti-bacterial activity of Vitis vinifera peel extract mediated synthesized ZnONPs.

Table 1:Antibacterial zone of inhibition and standard deviation of Vitis vinifera peel extract mediated synthesized ZnONPs.

Table 2:Antifungal zone of inhibition and standard deviation of Vitis vinifera peel extract mediated synthesized ZnONPs.

Zinc Oxide nanoparticles have the ability to anchor to the bacterial cell wall and subsequently penetrate it, thereby causing structural changes in the cell membrane like the permeability of the cell membrane and death of the cell. The formation of free radicals by the Zinc Oxide nanoparticles may be considered to be another mechanism by which the cells die. There have been electron spin resonance spectroscopy studies that suggested that there is formation of free radicals by the Zinc Oxide nanoparticles when in contact with the bacteria, and these free radicals have the ability to damage the cell membrane and make it porous which can ultimately lead to cell death. The cells are majorly made up of sulfur and phosphorus which are soft bases. The action of these nanoparticles on the cell can cause the reaction to take place and subsequently lead to cell death. Another fact is that the DNA has sulfur and phosphorus as its major components; the nanoparticles can act on these soft bases and destroy the DNA which would definitely lead to cell death. It has also been found that the nanoparticles can modulate the signal transduction in bacteria. It is a well-established fact that phosphorylation of protein substrates in bacteria influences bacterial signal transduction. Dephosphorylation is noted only in the tyrosine residues of gram-negative bacteria. The phosphotyrosine profile of bacterial peptides is altered by the nanoparticles. It was found that the nanoparticles dephosphorylate the peptide substrates on tyrosine residues, which leads to signal transduction inhibition and thus the stoppage of growth. It is however necessary to understand that further research is required on the topic to thoroughly establish the claims [13].
The present study concludes that Vitis vinifera peel extract can be used as source for synthesis. The spectroscopic characterization data such as UV-Vis, FT-IR, XRD, DLS, TEM also support the formation and stability of the bio-synthesized AgNPs and this type of NPs used for medical applications for drugs in future
Authors are very much thankful to Acharya N G Ranga Agricultural University Tirupathi for carrying, characterization (UV, FT-IR, DLS) and supporting of this work.
© 2018 E Davida. This is an open access article distributed under the terms of the Creative Commons Attribution License , which permits unrestricted use, distribution, and build upon your work non-commercially.
a Creative Commons Attribution 4.0 International License. Based on a work at www.crimsonpublishers.com.
Best viewed in